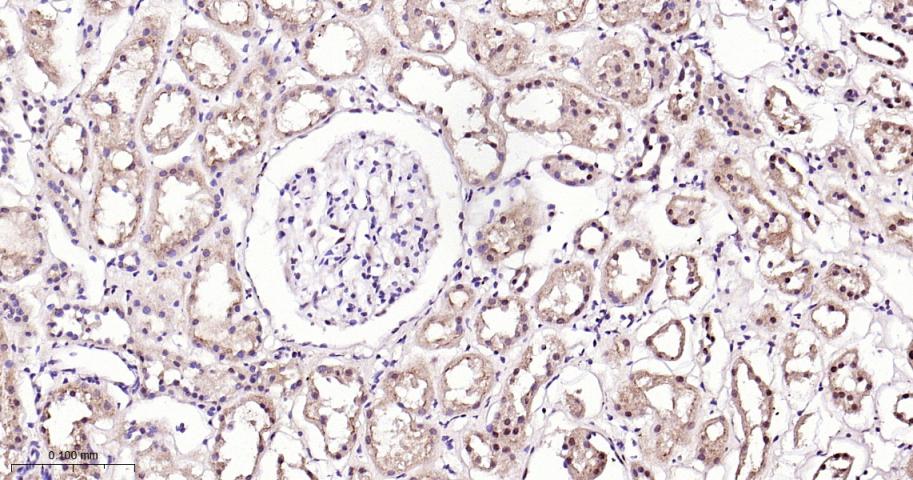
NADPH氧化酶4抗体

NADPH oxidase 4 Recombinant Rabbit mAb (一抗) - WB,IHC-P,IHC-F,IF | Bioss
Rrmab?兔单抗

货号:bsm-52390R
产品详情
相关标记
相关产品
相关文献
常见问题
概述
产品编号
bsm-52390R
产品类型
重组兔单抗
英文名称
NADPH oxidase 4 Recombinant Rabbit mAb
中文名称
NADPH氧化酶4抗体
英文别名
KOX; KOX-1; RENOX; NOX4_HUMAN; NOX4; Kidney oxidase-1 (KOX-1); Kidney superoxide-producing NADPH oxidase; Renal NAD(P)H-oxidase; 1.6.3.1; NOX4_MOUSE; Superoxide-generating NADPH oxidase 4; NOX4_RAT;
抗体来源
Rabbit
免疫原
A synthesized peptide derived from human NOX4: 510-578
亚型
IgG
性状
Liquid
纯化方法
affinity purified by Protein A
克隆类型
Recombinant
克隆号
2A4
理论分子量
67 kDa
检测分子量
60 kDa
浓度
1mg/ml
储存液
0.01M TBS (pH7.4) with 1% BSA, 0.02% Proclin300 and 50% Glycerol.
SWISS
Gene ID
保存条件
Shipped at 4℃. Store at -20℃ for one year. Avoid repeated freeze/thaw cycles.
注意事项
This product as supplied is intended for research use only, not for use in human, therapeutic or diagnostic applications.
数据库链接
产品介绍
还原型辅酶烟酰胺腺嘌呤二核苷酸磷酸(NADPH)oxidase 4:还原型辅酶烟胺腺嘌呤二核苷酸(Nicotinamide adenine dinucleotide reduced, NADH)位于线粒体膜内,是细胞能量代谢所必需的辅酶,主要功能是经电子传递链产生ATP。NADH在维持细胞生长、分化和能量代谢中起重要的作用。
背景资料
Nox4 is a renal gp91-phox homolog highly expressed at the site of erythropoietin production in the proximal convoluted tubule epithelial cells of the renal cortex. Nox4 is also expressed in fetal tissues, placenta, glioblastoma and vascular cells. Like gp91-phox, the enzymatic activity of Nox4 produces superoxide anions. In vascular cells, the addition of angiotensin II increases Nox4 expression, which suggests a role for Nox-4 in vascular oxidative stress response.

产品应用
| 应用 | 已检合格种属 | 预测种属 | 推荐稀释比例 |
|---|---|---|---|
| WB | Human | Mouse, Rat | 1:500-2000 |
| IHC-P | Human, Rat | Mouse | 1:50-200 |
| IHC-F | Human, Rat | Mouse | 1:50-200 |
| IF | Human, Rat | Mouse | 1:50-200 |
交叉反应
交叉反应: Human, Rat (predicted: Mouse)
相关产品
暂无相关产品
靶标
基因名
NOX4
蛋白名
NADPH oxidase 4
亚基
Interacts with, relocalizes and stabilizes CYBA/p22phox. Interacts with TLR4. Interacts with protein disulfide isomerase.
亚细胞定位
Endoplasmic reticulum membrane; Multi-pass membrane protein. Cell junction, focal adhesion. Cell membrane. Note=May localize to plasma membrane and focal adhesions.
组织特异性
EXpressed in brain, in all layers of the cerebellum, in pyramidal cells of the Ammon horn and in Purkinje cells (at protein level). Expressed in osteoclasts, leukocytes, kidney, liver and lung.
翻译后修饰
N-glycosylation is required for the function (By similarity).
相似性
Contains 1 FAD-binding FR-type domain.
Contains 1 ferric oxidoreductase domain.
Contains 1 ferric oxidoreductase domain.
功能
Constitutive NADPH oxidase which generates superoxide intracellularly upon formation of a complex with CYBA/p22phox. Regulates signaling cascades probably through phosphatases inhibition. May function as an oxygen sensor regulating the KCNK3/TASK-1 potassium channel and HIF1A activity. May regulate insulin signaling cascade. May play a role in apoptosis, bone resorption and lipolysaccharide-mediated activation of NFKB.
同靶标产品
相关文献
提示: 发表研究结果有使用 bsm-52390R 时请让我们知道,以便我们可以引用参考文章。作为回馈,资料提供者将获得我们送上的小礼品。
具体参考文献:bsm-52390R 被引用于1文献中